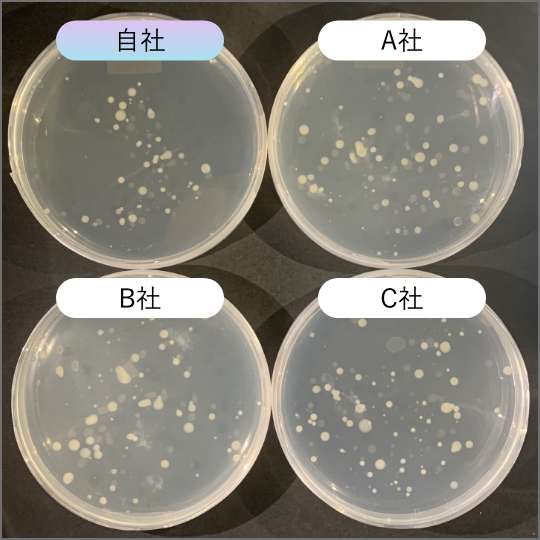
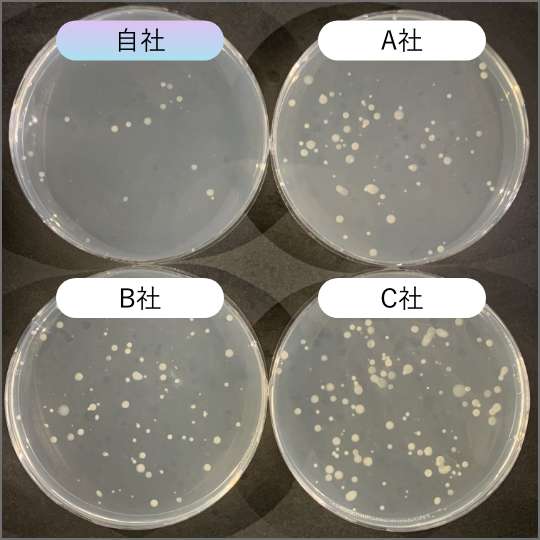
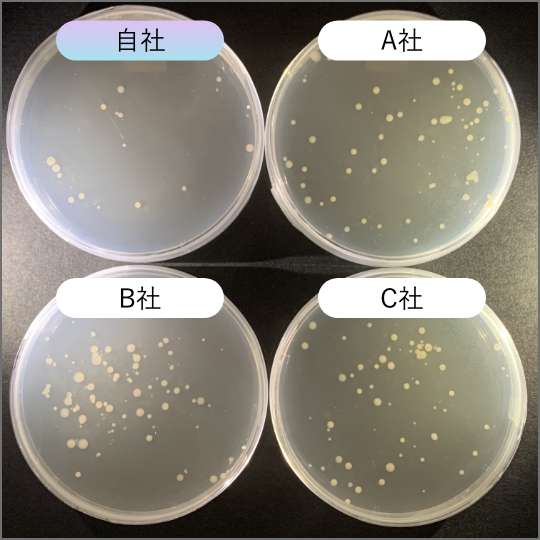
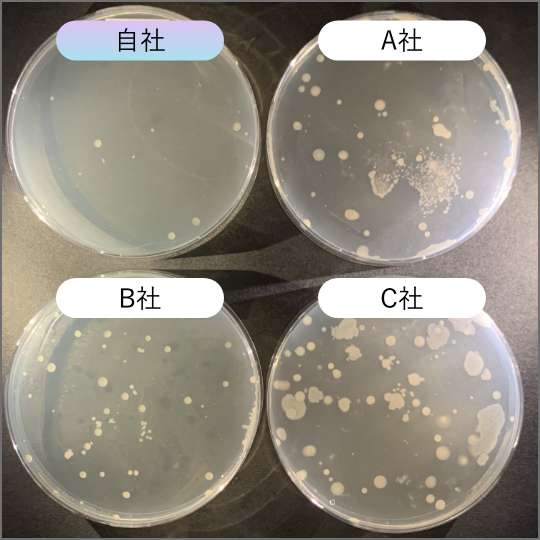

なぜ抗菌が可能なの?
抗菌処理の⽅法は、メーカーによってさまざま。
抗菌砂 サンドクリエは、銀イオンを利⽤した抗菌です。
銀イオンを利⽤する理由は
「銀は⼈体への影響がなく、消毒剤等を⽤いた
抗菌処理よりも安⼼・安全だから」

デジタルな遊びがあふれている現代だからこそ、
五感を使う『砂遊び』が注⽬されています!
抗菌砂とは「抗菌処理された砂」のこと。
抗菌の⽅法によって、無機系と有機系の2種類に
分けられます。
| 抗菌方法 | 特徴 | |
|---|---|---|
| 無機系 | 銀や銅等の金属を用いて抗菌処理 | 効果が長期間持続する |
| 有機系 | 化学合成した消毒液や抗菌剤を、 砂に焼き付けたり染み込ませたりして抗菌処理 |
即効性がある |
抗菌処理の⽅法は、メーカーによってさまざま。
抗菌砂 サンドクリエは、銀イオンを利⽤した抗菌です。
銀イオンを利⽤する理由は
「銀は⼈体への影響がなく、消毒剤等を⽤いた
抗菌処理よりも安⼼・安全だから」
砂には、さまざまな細菌や
ウイルスが付着しやすいからです。
とくに、⼩さいお⼦様だと、どれほど注意しても
⼝から砂が⼊り込んでしまう恐れも…。
お⼦さまが安全・健やかに砂遊びをするため
⼤事なお⼦様に砂遊びを楽しませたい
保護者様の安⼼のため
抗菌砂 サンドクリエはお役に⽴ちます!

銀イオンを利⽤した
マスク

銀イオンを利⽤した
消臭スプレー

銀を利⽤したアラザン
(ケーキのデコレーションに
使う銀⾊の粒)
だから 銀イオン抗菌砂 サンドクリエです。

砂遊びでもっとも活発に動かすのは「⼿」。
砂や道具を使って、⾃由に扱おうと試⾏錯誤して、手先の使い方を練習します。
お⼦さまにとって、砂は「不思議なもの」。
⼿先を使って遊ぶ⾏為は、⼼や脳の発達にもつながると⾔われています。

デジタルゲームやプラスチックのおもちゃは、遊び⽅がおおむね決まっています。
しかし、砂遊びの楽しみ⽅はさまざま。
お⼦さまの発想⼒・想像⼒で無限の遊び⽅があります。
テレビやゲームなどの、⼤⼈から与えられたイメージではありません。
「⾃分のイメージを、⾃分の⼿で形にしたもの」ということが、
お⼦さまの成⻑にとって重要な機会となるのです。

砂でイメージし、⾃由⾃在に扱うのは、⼤⼈でも難しいもの。
まして幼い⼦どもだと、なかなか⾃分の思い通りには扱えません。
しかし、⼦どもは遊びの中だからこそ、根気よく試⾏錯誤して、
楽しんでチャレンジしていきます。
時には失敗を繰り返しながらも、⼦どもは集中⼒・忍耐⼒を養っていくのです。
また、⼩さな成功体験の積み重ねが、⾃⼰肯定感の育成にもつながるでしょう。

テレビやゲーム、ネットで動画を楽しむだけなら、体を動かす機会は少なくなります。
砂遊びは、⽴ったり座ったり、⼿先だけでなく全⾝を使って遊びます。
さらに、バケツやスコップなどの道具もあれば、
運ぶ・積む・持つ・掘るなどの動作もあり、体のバランス感覚も⾃然と鍛えられます。
砂遊びの中から、⼦ども時代の体づくりだけでなく、
⽣涯に渡っての健康基盤・運動能⼒のアップにつながるでしょう。

砂遊びは、⼀⼈遊びもできれば、ご家族やお友達とも⼀緒に遊べます。
ご家族やお友達との遊びの中で、⾔葉を交わし、語彙を増やしていくでしょう。
また、共同的な作業、場所の分け合い、道具の貸し借り等、
さまざまなコミュニケーションが必要になります。
砂遊びを通して、⼼を豊かに育て、社会性が⾝についていくでしょう。

適切な抗菌処理が施されている抗菌砂は、
⻑期に渡って細菌の繁殖を抑制します。
【試験方法】既存の砂場にサンドクリエを散布・混合。一定期間ごとに砂中の
細菌数・大腸菌の測定を行い、抗菌持続性を評価。
| 検査機関 | 検査方法 | 採取場所 | 採取・検査年 |
|---|---|---|---|
| 株式会社北陸環境化学研究所 | 食品衛生検査指針 | K保育園 砂場 | 平成19年(2007年) |
| 段階 | 採取日 | 試験項目 | 結果 |
|---|---|---|---|
| 施工前 | 3月28日 | 細菌数 | 150,000/g |
| 大腸菌 | 陰性 | ||
| 施工1ヶ月後 | 4月25日 | 細菌数 | 300/g以下 |
| 大腸菌 | 陰性 | ||
| 施工3ヶ月後 | 6月26日 | 細菌数 | 1,900/g以下 |
| 大腸菌 | 陰性 | ||
| 施工6ヶ月後 | 9月26日 | 細菌数 | 11,000/g以下 |
| 大腸菌 | 陰性 |
| 試験名 | 内容 | 結果 |
|---|---|---|
| 経口毒性試験(ラット経口投与) | 口に入ってしまっても体に異常が出ないか | LD50=2000mg/kg超(ラットの死亡例なし) |
| 皮膚一次刺激性試験(ウサギ皮膚刺激) | 軽微な傷口から入っても皮膚に異常が出ないか | 無刺激性(ウサギに影響例なし) |
安⼼・安全な環境で、⼦どもたちを⾃由に遊ばせてあげるには、
「抗菌性能が弱い抗菌砂」では細菌の繁殖を抑えられないので、ダメ!
細菌に対し、強く⻑い抑制効果を持つ抗菌砂なら、
のびのび健康に⼦どもたちを遊ばせてあげられますよ!


「抗菌砂」として販売されているのに、
抗菌性能が弱い砂があること、ご存じですか?
【試験方法】各社抗菌砂を砂場の砂と混合。一定期間ごとに砂中の細菌数を測定。
【抗菌砂混合:24時間後】
【抗菌砂混合:2週間後】
【抗菌砂混合:1ヶ⽉後】
【抗菌砂混合:2ヶ⽉後】
いま市場には、⽣産元がわからない安価な抗菌砂もたくさんありますが、
他社製品は時間の経過とともに、細菌数の増加(抗菌力の低下)が見られます。
サンドクリエは時間が経過しても、細菌数の増加が見られず、高い抗菌力を維持しています。
サンドクリエは、完全国産・国内製造。徹底した品質・製造管理のもと、確かな抗菌砂をお届けします。
30代 女性
別の会社の砂を使っていましたが、化学薬品で抗菌しているらしく、買い替えを検討してました。銀イオンで安全と、クラウドファンディングで見て良さそうと思って購入しました。子供は大喜びで大人しく庭で遊んでくれますし、自分も安心して砂遊びをさせられて嬉しいです。
60代 男性
孫が砂遊びをしたがっていたが、娘夫婦は公園の砂は汚いからと反対。可哀そうに思っていたところ知人から紹介を受け、自宅で遊べる抗菌砂ならと思い贈る。娘は公園まで連れて行かなくて良いことや目の届く範囲で遊ばせられるのが良いと。婿さんは銀イオンでの抗菌効果に関心を持ってくれて、孫も自由に遊べて、贈って良かった。
30代 男性
コロナ禍もあって外で遊ぶのが難しくなり、家でゲームばかりすることになった子どもを見て購入。デジタルとは違う、手先だけじゃなく全身を使っての砂遊びは、情操教育にも良さそうと妻と話しました。一緒に届いた箱に抗菌砂を入れて遊べ、蓋も付いているので片付けも楽です。
20代 女性
下の子が産まれてなかなか公園に行けなくなってしまいました。そこで上の子に大好きな砂遊びをいつでもさせてあげたくてSAND CRIEを購入しました。ベランダやリビングで遊ばせていますが砂が飛び散るのも敷物を敷けば気にならないです。子どもが熱中して遊んでくれるので、自分の時間も取れるようになりとても助かっています。
成分
天然砂(抗菌薬剤は不使用)
抗菌処理
天然ゼオライトからの銀イオン
粒径
2㎜以下
抗菌砂 重量
10㎏(1袋)
A1
抗菌砂 サンドクリエは薬剤ではなく、銀イオンによって抗菌処理を⾏っています。仕組みは次のようになっています。
①砂に細菌が付着すると、砂に処理されている銀イオンが吸着し、菌の体内に取り込まれます。
②銀イオンが、細菌内の酵素と反応します。
③銀イオンが酵素の働きを阻害し、細菌の増殖を抑制します。光触媒による抗菌と違い、抗菌作⽤に太陽光を必要としないので、表⾯の砂だけでなく、内部まで抗菌化できます。
A2
⼀般的には、次のような細菌類に抗菌効果を確認しています。
また、インフルエンザウィルスなど、⼀部のウイルスに対しても不活化を確認しています。
ただし、より良い衛⽣的向上の観点から、砂遊び後のお⼦様には⼗分なうがい・⼿洗いを指導されることは推奨しております。
A3
⼤腸菌、⻩⾊ブドウ球菌、アオカビなど、様々な細菌や真菌に対して効果を発揮します。
また、野⿃のフンに含まれるウイルスに対しても効果が期待できます。
ただし、「抗菌」とは、菌を積極的に分解していく殺菌効果ではありません。
A4
はい、影響はありません。
銀は⼈体に安全性が⾼い物質と知られています。
例えば、デコレーションケーキに使⽤される銀⾊の粒アラザンや、昔ながらの清涼剤である仁丹の表⾯⾊には、銀(Ag)が利⽤されています。
A5
サンドクリエの抗菌効果は、分解や溶け出すことはなく抗菌効果を持続します。
抗菌に消費される銀は⾮常に微量なので、⻑期にわたって抗菌効果は続きます。
しかし、子供の持ち出しで、その効果を⼗分に発揮できなくなっていきます。
⼗分な抗菌能⼒を維持するためには、定期的に補充することが必要です。
A6
抗菌砂 サンドクリエは、屋内・屋外どちらでも使⽤可能です。
弊社では、こども園や児童館等での屋外砂場での利⽤実績もございます。
屋外での使⽤の場合は、未使⽤時はフタやシートなどで表⾯を覆っておくと⾶び散りを防げますので推奨しております。
A7
リビング等の⼀⾓といった⼩スペースでも楽しめると、お客様のお声をいただいております。
付属のSand Boxに抗菌砂を入れてご使用ください。Sand Boxは蓋付きなので、片付けも簡単です。
A8
お⽀払い⽅法は、クレジットカードとなります。
関連詳細は、抗菌砂 サンドクリエの販売サイト、ネットショップBASE(ベイス)の規約に準拠します。
A9
送料は、次のようになっております。
A10
セットで同⼀箇所への配送となりますので、⼤変申し訳ございませんが、別々の配送先をご指定ください。
A11
可能です。購⼊時に希望のお届け先をご記⼊ください。
ただし、配送先への事前通知はございませんので、受け取り拒否防⽌のため、事前にご購⼊様からご⼀報をお願い致します。
A12
霧吹き等で⽔分を含ませると固まりやすくなります。
濡れた砂をSandBoxに⼊れっぱなしにしておくと、⽔分によってSandBoxが弱くなることがあります。
その場合は、砂を同封のビニール袋に⼊れてご使⽤ください。
A13
⼤変申し訳ございませんが、対応しておりません。